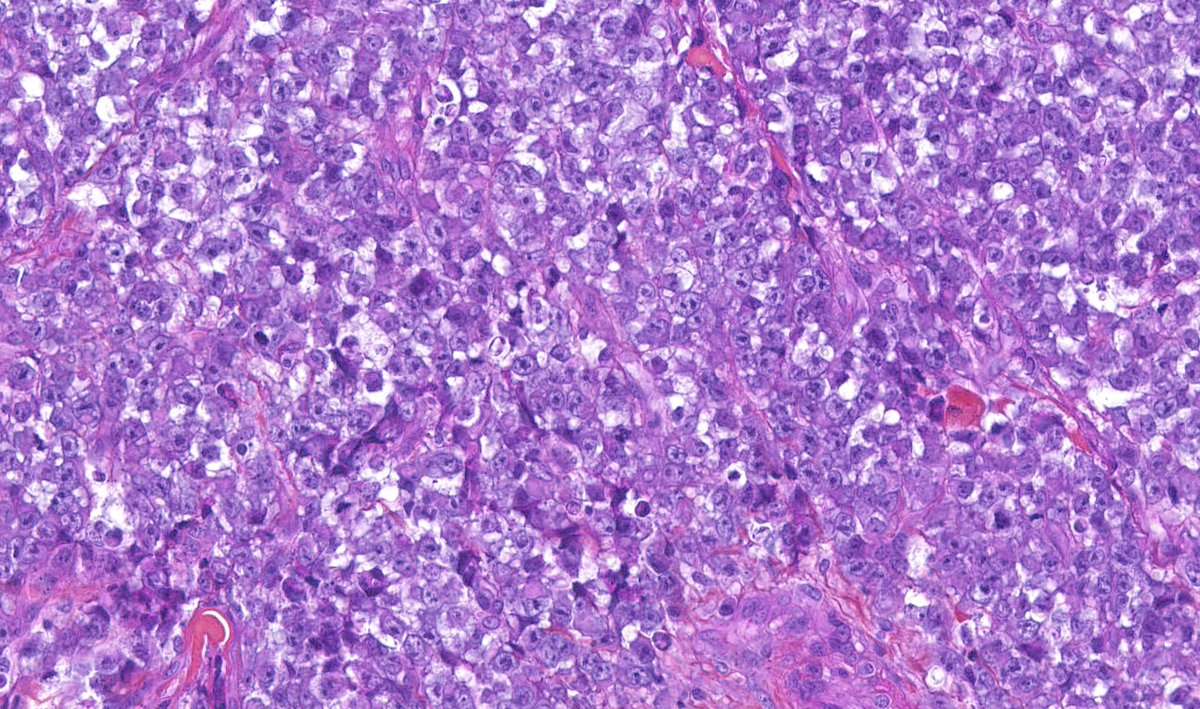
Malignant cutaneous myoepithelioma : ulcerated skin neoplasm - plasmacytoid, epithelioid, spindle &amp; small undifferentiated cytology - chondroid matrix - high mitotic activity (&gt;15.mm2) - geographic necrosis #dermpath #bstpath

Dermatopathologie 🇫🇷
@dermatopathfr
Club de dermatopathologie français - Association pour le Développement de la DermatoPathologie (ADDP) #dermpath #francophonepath
ID: 1338075388883443713
http://dermatopathologie.fr 13-12-2020 10:56:52
22 Tweet
250 Followers
26 Following



Assises de pathologie 2021 : inscrivez vous :) --> assisesdepathologie.fr Le thème de cette année est la DERMATOPATHOLOGIE ! 🎉 @BeatriceVergier @battistellamxm Nicolas Macagno, MD, PhD Arnaud de la Fouchardiere MD, PhD Annales de Pathologie #francophonepath #pathtwitter






>100 participants connectés au club de dermatopathologie 🤩 #assisespathologie2021 @BeatriceVergier Maxime Battistella MD, PhD







Chères amies, chers amis, il est temps de s’inscrire à l’EPU de l’AIP-DF sur la pathologie mélanocytaire cutanée ! Date : 8 avril 2022 Inscrivez vous : aip-df.com/actualites/17-… Cecile Badoual @BeatriceVergier Arnaud de la Fouchardiere MD, PhD Annales de Pathologie Calvo Jessica Annales de Dermatologie et de Vénéréologie